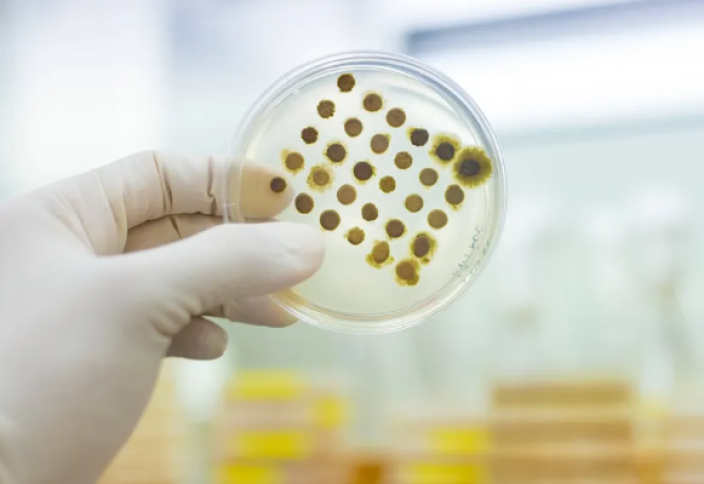
По Европе распространяется опасный грибок, поражающий пах и ягодицы

|
По Европе распространяется опасный грибок, поражающий пах и ягодицы
|
Опасная грибковая инфекция, которую западные массмедиа называют «супергрибком», стремительно распространяется по Европе. Об этом пишет The Sun со ссылкой на источники.
По данным газеты, новый штамм Trichophyton indotineae («индотинный трихофитон») устойчив к обычным лекарствам, начинает проявляться в виде кольцевидных пятен в паху или на ягодицах, которые затем распространяются по всему телу.
Инфекция передается как при прямом контакте с зараженным человеком (при объятиях, во время секса), так и опосредованно — через вещи и поверхности, с которыми контактировал инфицированный.
Фактически, это тяжелая разновидность лишая, знакомого медицине много веков, заметили журналисты. Вместе с тем, добавили они, современный штамм стал куда опаснее и устойчивее.
Многие классические препараты не действуют на грибок, высыпания держатся неделями и трудно поддаются лечению.
За последние три года число заболевших выросло примерно на 500%. Некоторые случаи (около 26%) заражения были связаны с поездками в Южную Азию или контактами с путешественниками оттуда.
В дальнейшем случаи заражения были зафиксированы в США, Британии, Франции и Германии.













